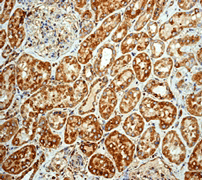

> Antigen, Antibodies, ELISA, Western Blot > Primary Antibody > Monoclonal Antibodies > Calreticulin AntibodyBrand |
Leading Biology | Catalog Number |
APR14312G |
Product Type |
Monoclonal Antibodies | Field of Research |
|
Product Overview |
We constantly strive to ensure we provide our customers with the best antibodies. As a result of this work we offer this antibody in purified format.
We are in the process of updating our datasheets. If you have any questions regarding this update, please feel free to contact our technical support team.
This product is a high quality Calreticulin antibody.
|
||
Molecular Weight |
48142 Da
|
||
Cellular Localization |
Antigen Cellular Localization:
Endoplasmic reticulum lumen. Cytoplasm, cytosol. Secreted, extracellular space, extracellular matrix. Cell surface. Sarcoplasmic reticulum lumen. Note=Also found in cell surface (T cells), cytosol and extracellular matrix Associated with the lytic granules in the cytolytic T-lymphocytes
|
||
Host |
Rabbit
|
||
Species Reactivity |
Human, Mouse, Rat
|
||
Target |
A synthetic peptide corresponding to residues in human Calreticulin was used as an immunogen.
|
||
Clone |
EPR3924
|
||
Symbol |
CRTC
|
||
GeneID |
|||
UniProt ID |
|||
Function |
Calcium-binding chaperone that promotes folding, oligomeric assembly and quality control in the endoplasmic reticulum (ER) via the calreticulin/calnexin cycle. This lectin interacts transiently with almost all of the monoglucosylated glycoproteins that are synthesized in the ER. Interacts with the DNA-binding domain of NR3C1 and mediates its nuclear export. Involved in maternal gene expression regulation. May participate in oocyte maturation via the regulation of calcium homeostasis (By similarity).
|
||
Summary |
Calreticulin is a molecular Ca+ binding chaperone promoting folding, oligomeric assembly, and quality control in ER. Calreticulin is a highly versatile lectin-like chaperone, and it participates during the synthesis of a variety of molecules, including ion channels, surface receptors, integrins and transporters (1). Calreticulin indeed provides up to 45% of the Ca2+-buffering capacity for a pool of the IP3-sensitive Ca2+ inside the ER (2). Calreticulin also functions in cell adhesion, integrin-dependent Ca2+ signaling and steroid-sensitive gene expression (1).
|
||
Form |
50 mM Tris-Glycine (pH 7.4), 0.15 M NaCl, 40% Glycerol, 0.01% sodium azide and 0.05% BSA. |
||
Storage & Stability |
Store at +4°C short term. For long-term storage, aliquot and store at -20°C or below. Stable for 12 months at -20°C. Avoid repeated freeze-thaw cycles.
|
||
Applications |
WB, IF, IHC
|
||
Dilution |
WB~~1:1000~10000
IHC~~1:250~500
|
||
Synonyms |
Calreticulin, CRP55, Calregulin, Endoplasmic reticulum resident protein 60, ERp60, HACBP, grp60, CALR, CRTC
|
||
Images |

Fig 1. Western blot analysis on (A) SH-SY5Y, (B) HL-60, (C) HepG2, (D) HeLa, (E) Fetal kidney and (F) Fetal brain lysates using anti-Calreticulin RabMAb (Cat. APR14312G). 
Fig 3. Immunofluorescent staining of HeLa cells using anti-Calreticulin RabMAb (Cat. APR14312G).
Fig 2. Immunohistochemical analysis of paraffin-embedded human kidney tissue using anti-Calreticulin RabMAb (Cat. APR14312G). |
||
Specification |
|||
Quantity |
|
||
| Select | Brand | Catalog No. | Product Name | Pack Size | Type | Field of Research | Specification | Quantity | Price(USD) | |
| 1 | Leading Biology | APG02467G | CCK4 / PTK7 Antibody (clone 4F9) | 50 μl | Monoclonal Antibodies |
|
$495.00 | Add Ask | ||
| 2 | Leading Biology | AMM04683G | GALT Antibody (clone 4C11) | 50 μg | Monoclonal Antibodies |
|
$545.00 | Add Ask | ||
| 3 | Leading Biology | AMM01402G | Vimentin (Mesenchymal Cell Marker) Antibody - With BSA and Azide | 50 ug | Monoclonal Antibodies |
|
$395.00 | Add Ask | ||
| 4 | Leading Biology | APR08280G | LTA4H / LTA4 Antibody (clone 9G8) | 50 μl | Monoclonal Antibodies |
|
$495.00 | Add Ask | ||
| 5 | Leading Biology | AMM00172G | CD1a / HTA1 (Mature Langerhans Cells Marker) Antibody - With BSA and Azide | 50 ug | Monoclonal Antibodies |
|
$395.00 | Add Ask | ||
| 6 | Leading Biology | AMM05750G | CEBPA Antibody | 100 μl | Monoclonal Antibodies |
|
$545.00 | Add Ask |
 Leading Biology Inc.
2600 Hilltop DR, Building G, B Suite C138
Richmond, CA, 94806
Tel: 1-661-524(LBI)-0262
Email: info@leadingbiology.com
Leading Biology Inc.
2600 Hilltop DR, Building G, B Suite C138
Richmond, CA, 94806
Tel: 1-661-524(LBI)-0262
Email: info@leadingbiology.com
Complete this form and click send to ask us a question, request a quote or simply say hello.

You have 0 item in your cart

You have 0 item in your inquiry list
